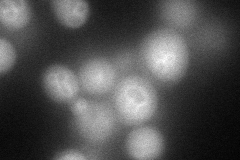
YBR077C
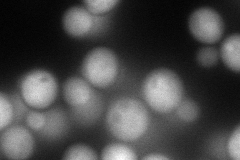
YBR077C
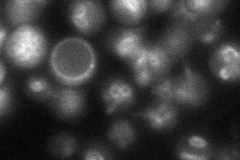
YBR077C
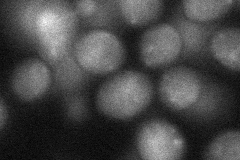
YBR077C
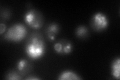
YBR077C
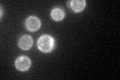
YBR077C

View description
Component of the EGO complex, which is involved in the regulation of microautophagy, and of the GSE complex, which is required for proper sorting of amino acid permease Gap1p; gene exhibits synthetic genetic interaction with MSS4
Localization:
Intensity:
Fold change:
Significance:
-
C’ GFP library in SD

vacuole membrane53.73 -
N' NOP1pr-GFP in SD
vacuole membrane95.1384 -
N' TEF2pr-mCherry in SD
cytosol,vacuole membrane125.036 -
N' NATIVEpr-GFP in SD
vacuole membrane48.4276 -
N' TEF2pr-VC and Cyto-VN in SD
cytosol37.3074 -
C’ GFP library in SD+DTT
vacuole membraneN/AN/ANo -
C’ GFP library in SD+H2O2

vacuole membraneN/AN/ANo -
C’ GFP library in Starvation Media
vacuole membraneN/AN/AYes -
C’ GFP library on the background of Pup2-DaMP

vacuole membrane -
C’ GFP library on the background of CCT mutant

vacuole membraneN/AN/ANo
